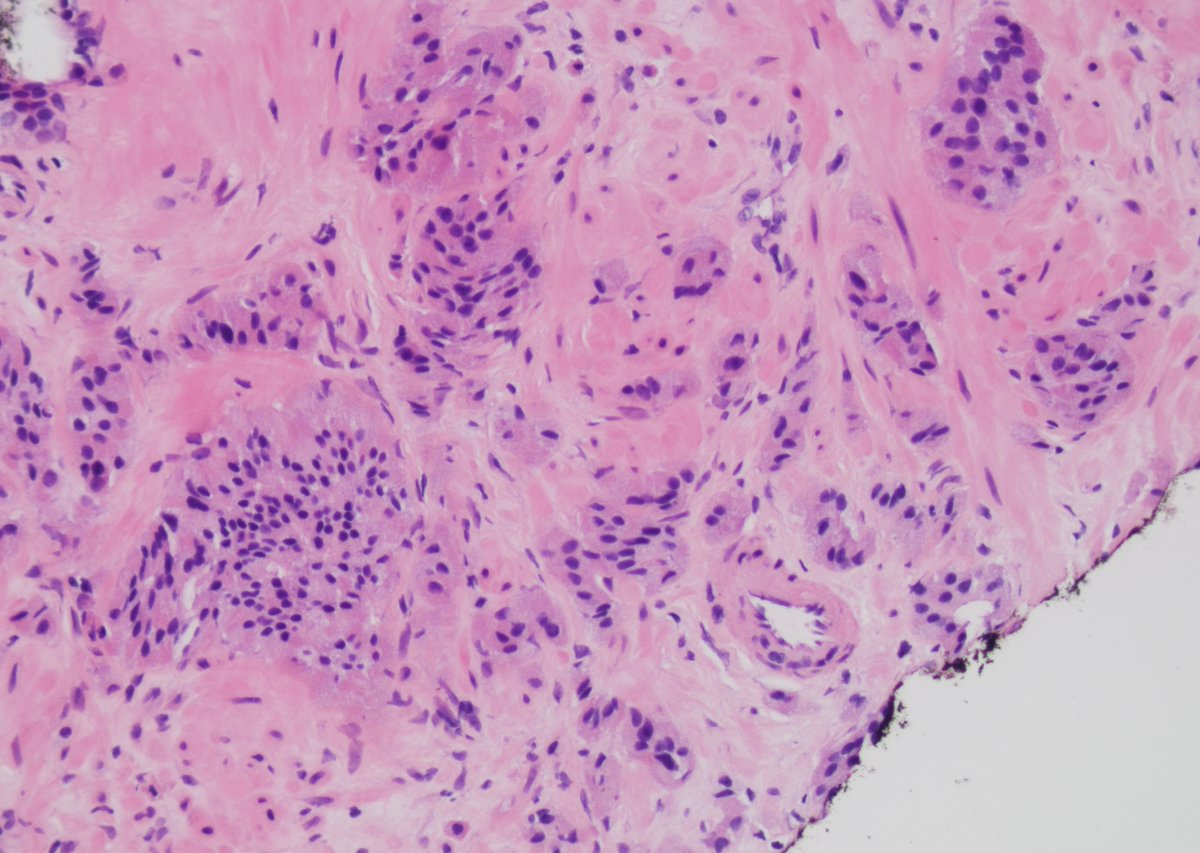
Andres Matoso tweet media

Angehefteter Tweet

Prostate Cell News focuses on recent scientific journal articles covering prostate cell biology, cancer research, and related disease models.
If you want to keep up with recent scientific discoveries in this field, then subscribe to receive free email newsletters delivered straight to your inbox. 📥
bit.ly/4kkWMEu

English